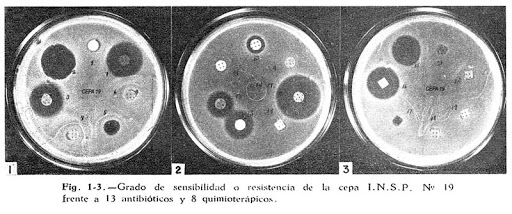
Resistencia bacteriana
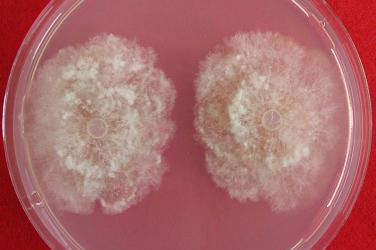
Resistencia fúngica

-
Primeros intentos de la explicación racional de las enfermedades en las plantas en sus libros "Historia Plantarum" y "De Causis Plantarum"
-
Las partículas de polvo que tomó a partir de
un hongo y depositó en rebanadas de melón recién cortadas,
reproducían a menudo la misma clase de hongo, concluyendo que dichas partículas eran las semillas (esporas) del hongo y que estas eran transportadas en el aire. -
Needham encuentra estos nematodos en el interior de los granos de trigo.
-
Este evento causó la pérdida de los cultivos de papa en Irlanda y consecuentemente la pérdida de muchas vidas sí como la emigración de la población irlandesa a USA. Todos estos factores propiciaron el interés en la investigación y el inicio de la fitopatología.
-
DeBary descubre al hongo causante de el tizón tardío de la papa.
-
Esta enfermedad introducida a Europa desde los Estados Unidos causa devastadoras pérdidas de los viñedos debido a su gran capacidad germinativa.
-
Millardet observa que al rociar la vid con esta mezcla azulosa de cal y sulfato de cobre se evitaba la rapiña y por lo tanto se lograba la conservación de las hojas de esta planta.
-
Mayer reprodujo la enfermedad del mosaico del tabaco inyectando jugo de plantas enfermas a plantas sanas, al ver que no producía hongo las plantas enfermas ni el caldo de cultivo este concluye que el causante de la enfermedad es una bacteria.
-
DeBary encuentra el origen de la podredumbre de cultivos de zanahorias en este hongo, también concluye que se alimenta de los cultivos al producir enzimas y toxinas que afectan a estas plantas
-
Beijerinck demuestra que el causante del mosaico del tabaco es causada por microorganismos más pequeños que una bacteria a los cuales denomina virus.
-
Jones descubre la actividad de estas enzimas producidas por bacterias en la pudrición blanda de hortalizas
-
Brown encuentra la importancia de estas enzimas generadas por hongos en las enfermedades de plantas
-
Kausche y colaboradores observan estas partículas en un microscopio electrónico
-
Se empiezan a usar antibióticos para el tratamiento de fitopatologías
-
Se descubre algunas bacterias con capacidad de resistencia a los antibióticos dificultando el tratamiento de las fitopatologías.
-
Vanderplanck define dos tipos de resistencia de las plantas frente a patógenos: la resistencia vertical que es fuerte y específica, y la resistencia horizontal que es débil pero resistente a variedad de especies de patógenos
-
Se descubren cepas fúngicas resistentes a fungicidas de uso común
-
Kulka y von Schmeling introducen el primer fungicida sistémico
-
Doi y colaboradores encuentran micoplasmas flotando en el floema de plantas afectadas por chicharritas
-
Davis y colaboradores encuentran los espiroplasmas como causantes de la enfermedad del achaparramiento del maíz
-
El virus del mosaico de la coliflor se convierte en el primer virus fitopatógeno completamente secuenciado determinando con exactitud la secuencia de sus 8000 pares de bases
Want to make a timeline like this?
Use Timetoast to turn dates, events, milestones, and phases into a clear visual timeline you can build and share. Timetoast is a timeline maker for work, school, research, and stories.